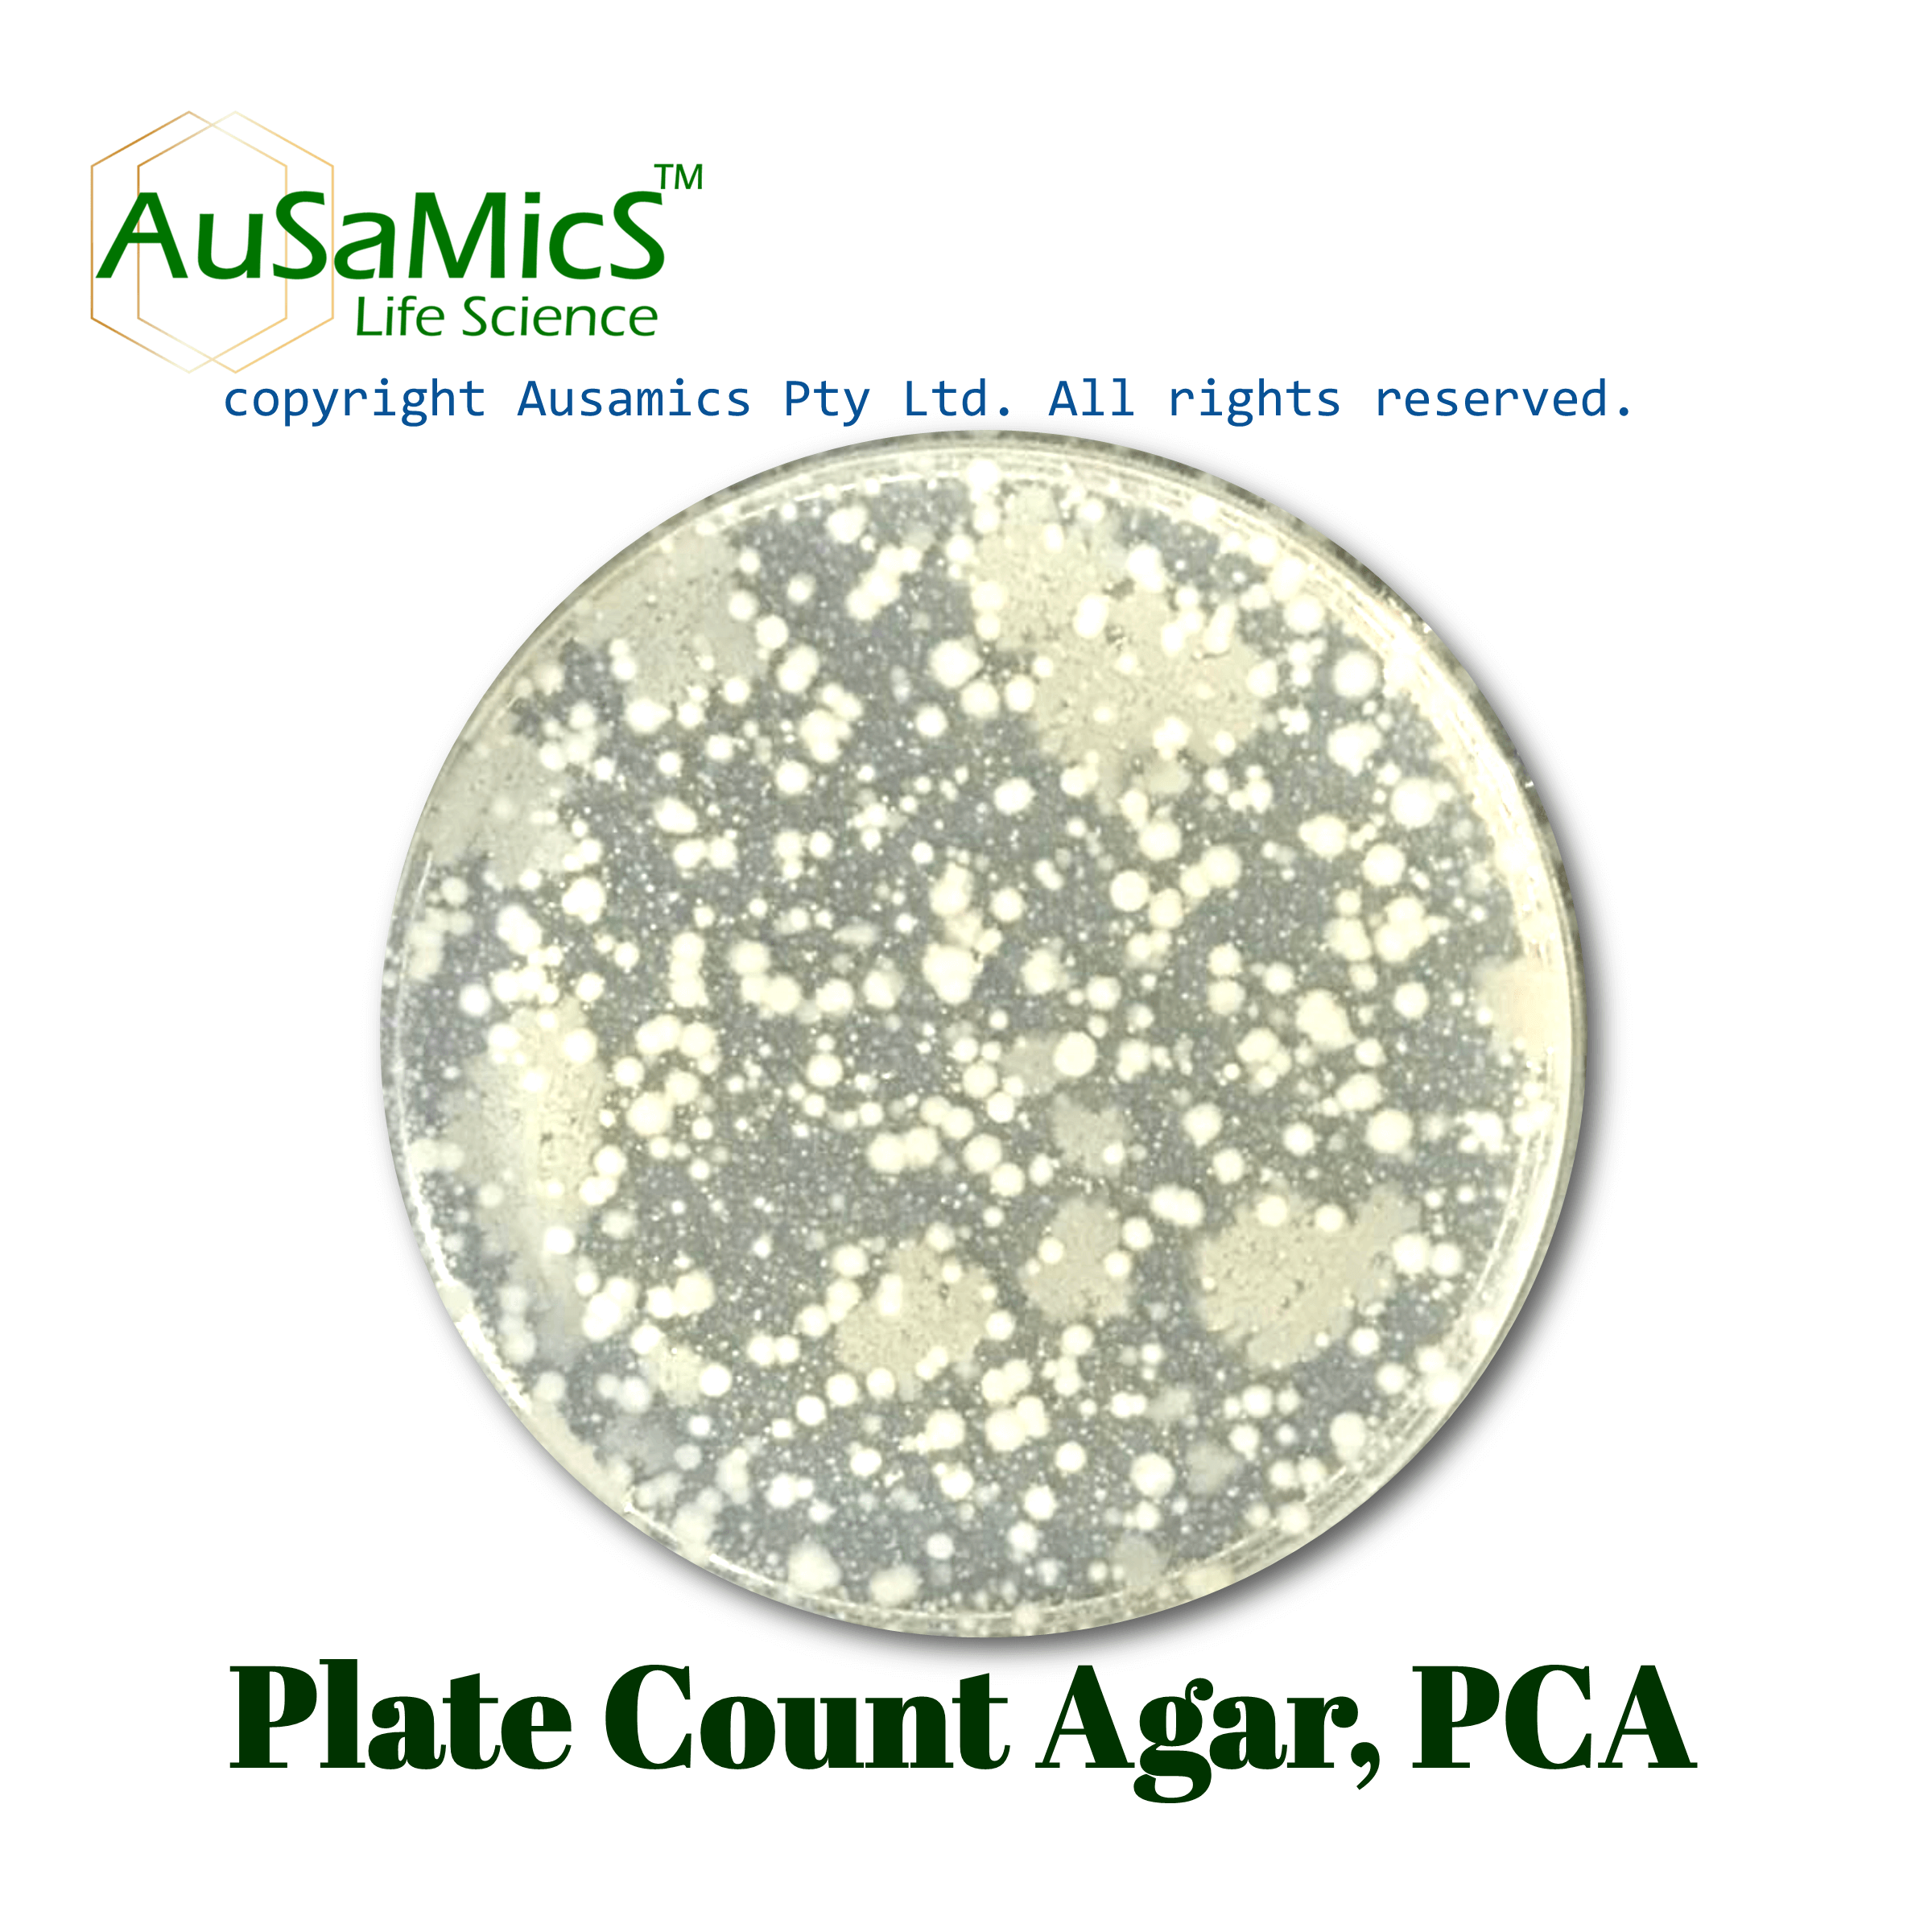
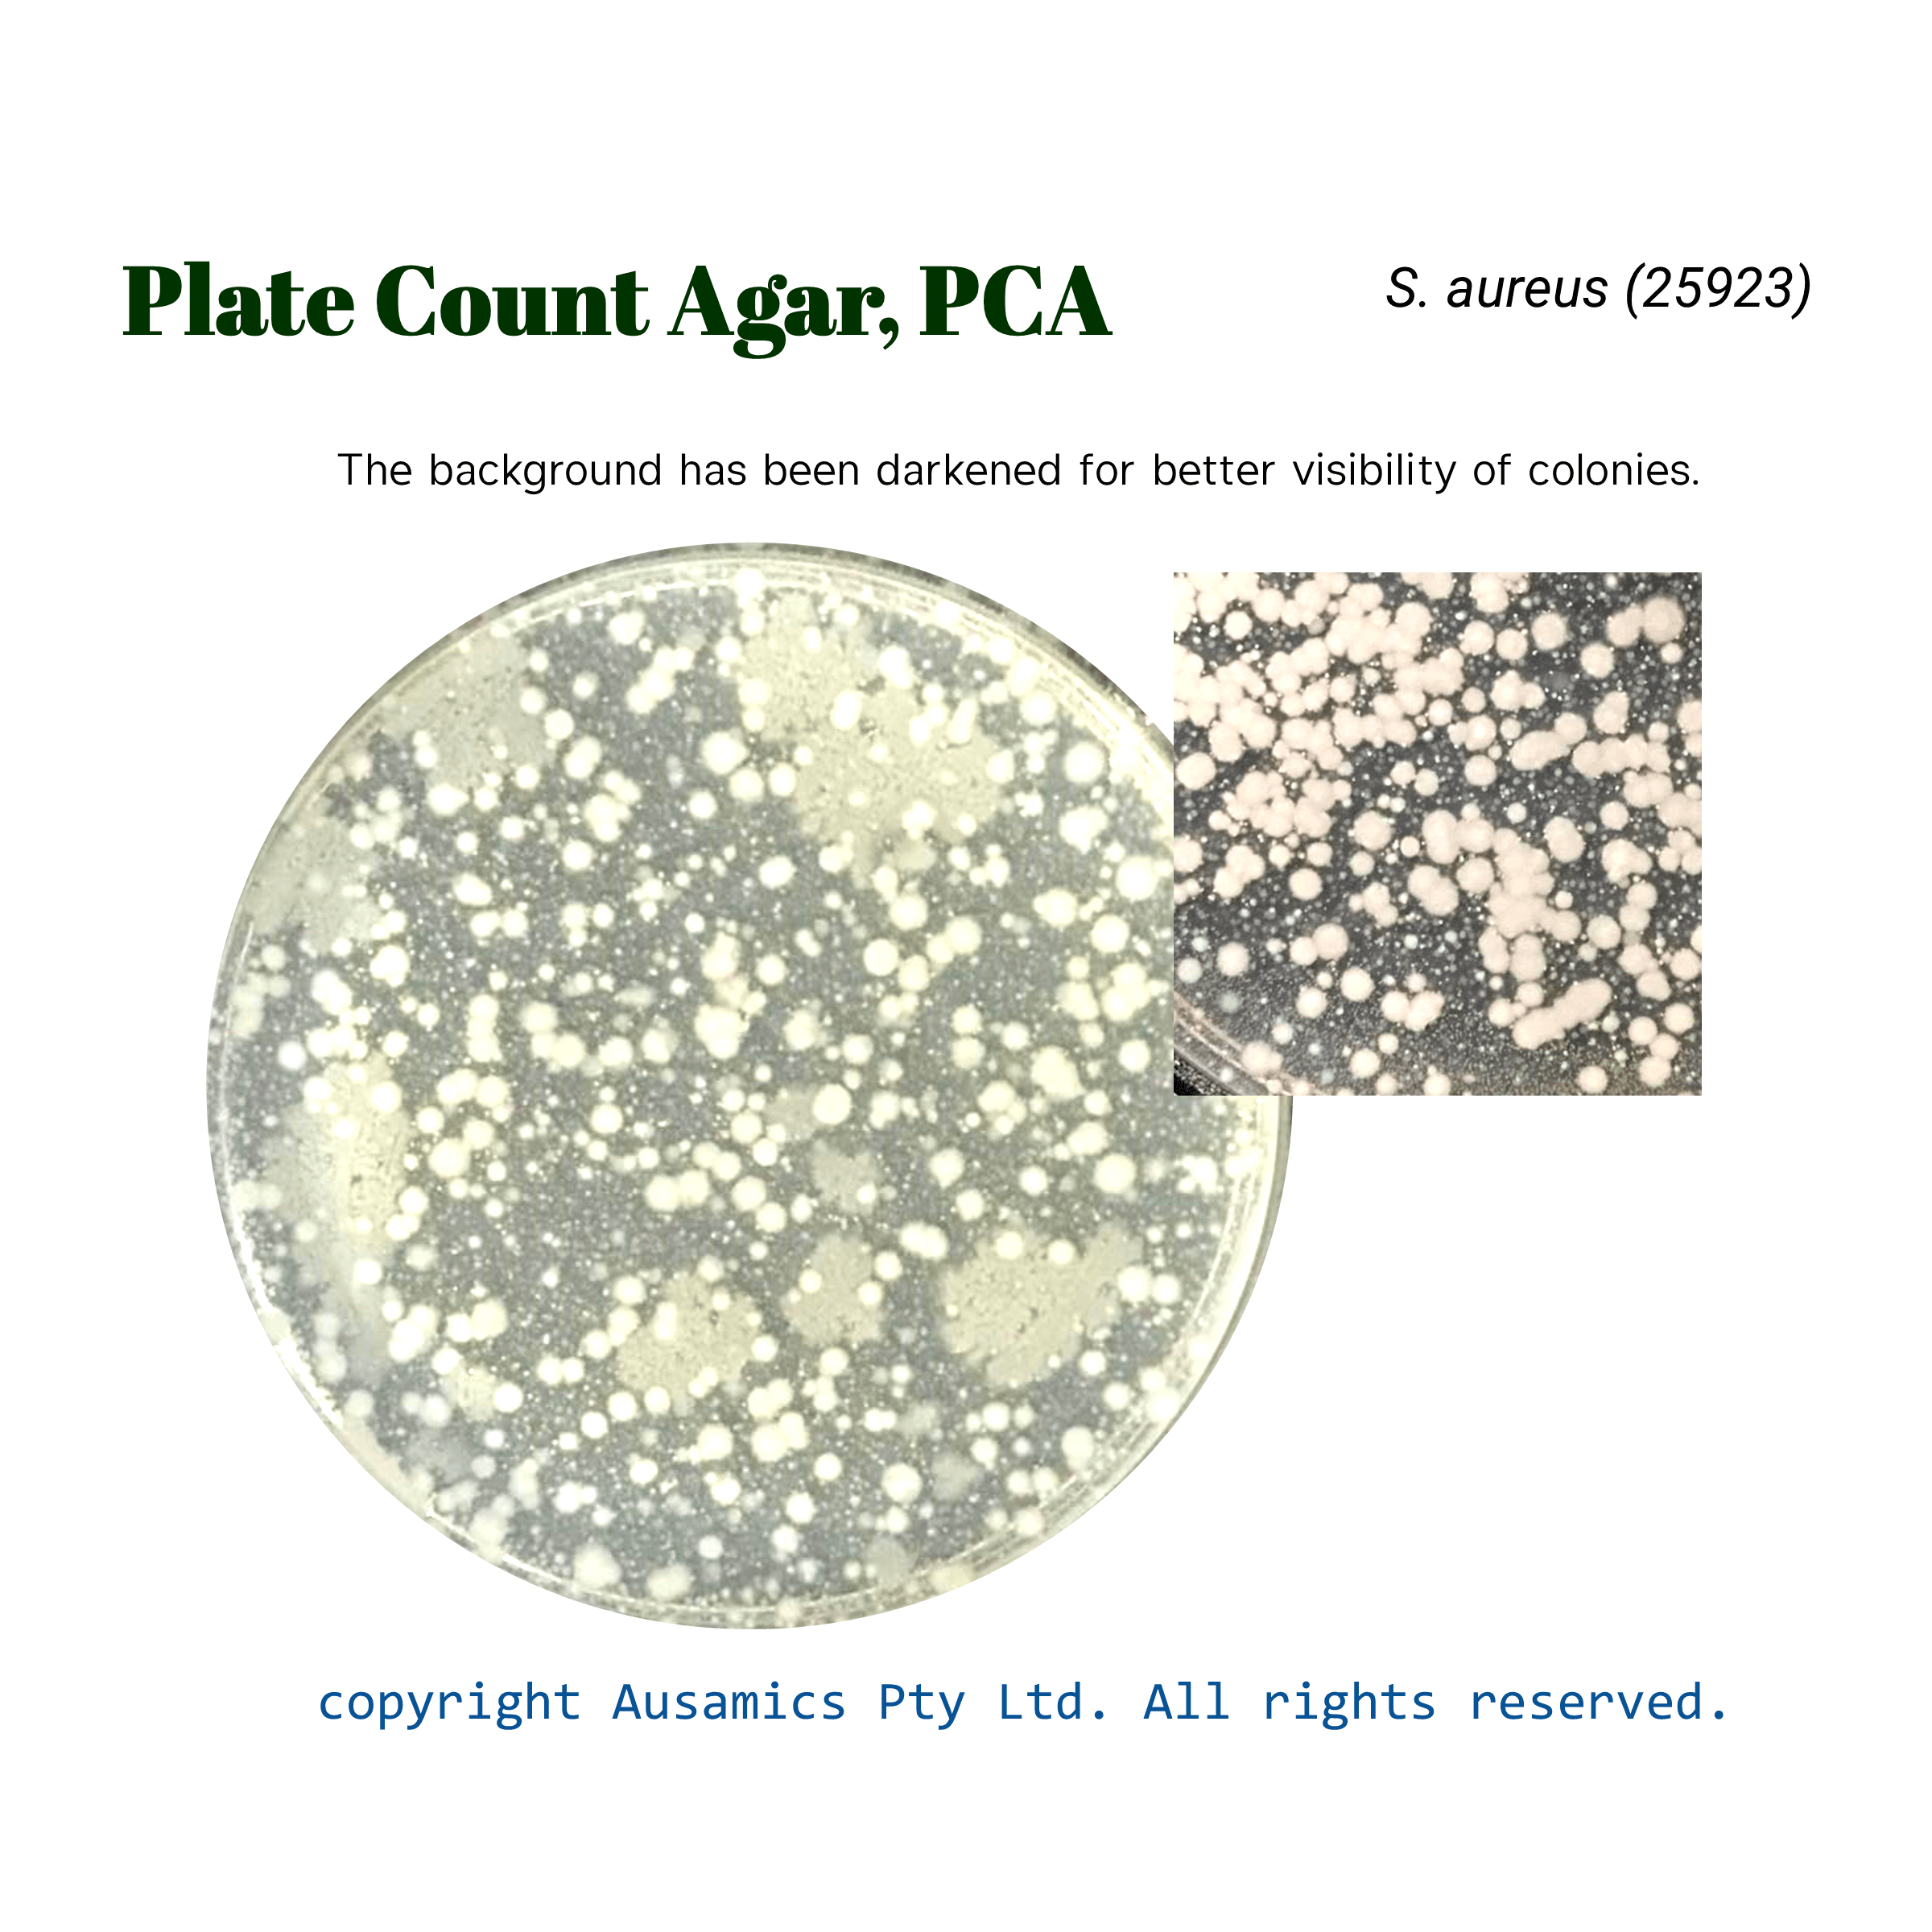

Plate Count Agar
For obtaining microbial plate count from milk and dairy products, foods, water and other materials pf sanitary importance.
- Description
- Composition
- Quality Control
- Microbial Test Results
An essential culture medium for counting microorganisms in different samples is plate count agar. Its formulation has changed to do away with the necessity for milk in compliance with the suggestions made by Buchbinder et al. This composition has been changed to promote the growth of a broad variety of microorganisms without the need for additional ingredients, in compliance with the guidelines established by APHA, ISO, and AOAC. In accordance with the guidelines of the FDA’s Tryptone Glucose Yeast Agar and the “Standard Methods for the Examination of Dairy Products,” it is the best option for plate counts in a variety of sample types.
The well-balanced elements of this medium are the reason for its adaptability. Yeast extract is a source of necessary B-complex vitamins, and it mixes with pancreatic digest casein, which provides nitrogen and carbon sources, amino acids, and essential nutrients. Agar acts as the solidifying agent, while glucose promotes the growth of bacteria. The APHA-recommended pour plate procedure ensures accurate results. This agar works well with food and animal feed samples as well as for determining the microbiological content of water and other materials. It complies with recognized standards including EN ISO 4833 and ISO 17410. It is also known as Casein-Peptone Dextrose Yeast Agar and Tryptone Glucose Yeast Agar. It offers a nutrient-rich culture medium free of inhibitors for microbial enumeration.
Storage
Keep the container at 15-30 °C and prepared medium at 2-8 °C.
| Composition | (gr/L) |
| Pancreatic Digest of Casein | 5 |
| Yeast Extracts | 2.5 |
| Glucose | 1 |
| Agar | 14 |
| Final pH at 25°C | 7.0 ± 0.2 |
| Dehydrated Appearance | Light beige, free-flowing, homogeneous. |
| Prepared Appearance | Light amber, slightly opalescent. |
| Reaction of 2.25% Solution at 25°C | pH 7.0 ± 0.2 |
| For 18 to 48 hours, incubate at 35 ± 2°C. | |
| Organism (ATCC) | Recovery |
| Lactobacillus johnsonii (11506) | Good |
| Staphylococcus aureus (25923) | Good |